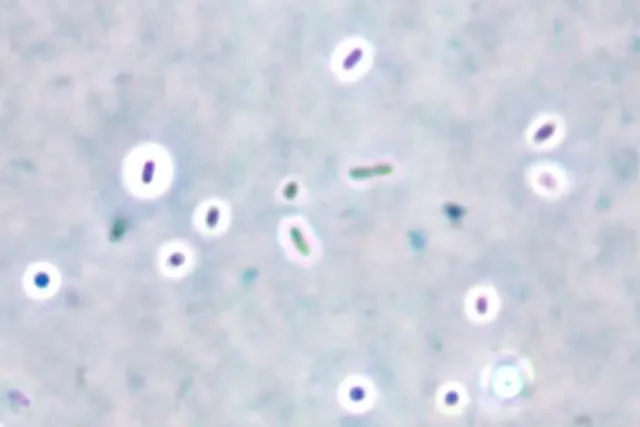
Capsule stain - Capsule staining by India ink method (at 1000x magnification)

Capsule stain is a type of differential stain which uses acidic and basic dyes to stain the background and bacterial cells, respectively, so that presence of the capsule is easily visualized. The capsule is synthesized in the cytoplasm and secreted outside the cell, where it surrounds the bacterium.
Most capsulated bacteria have a capsule made up of a polysaccharide layer, but some bacteria have a capsule made up of polypeptide or glycoprotein. Capsules are associated with virulence in several microorganisms, including Streptococcus pneumoniae and Neisseria meningitides, because capsules resist phagocytosis.****
In capsule staining procedure “we do not heat fix and rinse the smear with water” as heat and water may dislodge capsules from bacteria.
Principle of Capsule Stain
Bacterial capsules are non-ionic, so neither acidic nor basic stains will adhere to their surfaces. Therefore, the best way to visualize them is to stain the background using an acidic stain*(e.g., Nigrosine, congo red)* and tostain the cell itself using a basic stain*(e.g.,crystal violet, safranin, basic fuchsin, and methylene blue).*

Various types of methods are available for the demonstration of bacterial capsules. The results (stain of the cells, background, and capsule) depend on the method used. Two commonly used methods are discussed here:
A. India ink method
In this method, two dyes, crystal violet, and India ink are used. The capsule is seen as a clear halo around the microorganism against the black background. This method is used for demonstrating Cryptococcus.
- The background will be dark (color of India ink).
- The bacterial cells will be stained purple (bacterial cells take crystal violet-basic dyes as they are negatively charged).
- The capsule (if present) will appear clear against the dark background*(capsule does not take any stain).*
Expert opinion: Tasha Sturm, Microbiologist at Cabrillo College, “I use Nigrosin instead of India ink as Nigrosin gives a more even background and spreads little easier”. Read details in the comment section.
B. Anthony’s stain method
In this type of capsule staining procedure, the primary stain is crystal violet, and all parts of the cell take up the purple crystal violet stain. There is no mordant in the capsule staining procedure. A 20% copper sulfate solution serves a dual role as both the decolorizing agent and counterstain. It decolorizes the capsule by washing out the crystal violet, but will not decolorize the cell. As the copper sulfate decolorizes the capsule, it also counterstains the capsule. Thus, the capsule appears as a faint blue halo around a purple cell.
Materials and Reagents
- Test bacteria: 36-48 hour culture of capsulated bacteria e.g. Klebsiella pneumoniae growing on a slant of****EMB agar or culture of other capsulated bacteria and non-capsulated bacteria [Note: Growing Klebsiella pneumoniae in milk-based media (e.g. Skim milk) increase its capsule size, making it easier to visualize.]
- Stain solutions: Depending on the method used (crystal violet, India ink, Nigrosin, copper sulfate, Basic carbol fuschin solution, methylene blue solution, etc).
- Microscopic slides
- Inoculating loop
- Light Microscope with 100x objective lens (oil immersion)
- Immersion oil
- Gas burner
- Tissue paper
Capsule Stain procedure
A. India Ink Method
- Place a single drop of India ink on a clean microscope slide, adjacent to the frosted edge.
- Using a flamed loop and sterile technique, remove some Klebsiella pneumoniae from culture tube or plate and mix it into the drop of India ink. Be sure there are no large clumps of organism, but try to avoid spreading the drop.
- Place the end of another clean microscope slide at an angle to the end of the slide containing the organism. Spread out the drop out into a film. This is done by contacting the drop of India ink with the clean microscope slide and using the capillary action of the dye/ slide to spread the India ink across the smear.
- Allow the film to air dry (will take 5-7 minutes). DO NOT heat or blot dry! Heat will melt the capsule!
- Saturate the slide with crystal violet for 1 minute and rinse slightly & very gently with water. Be cautious water may remove the capsule from the cell.
- Let the slide air dry for a few minutes. DO NOT blot the slide! Blotting will remove the bacteria from the slide and/or distort the capsule.
- Observe the slide under oil immersion.
Results: Look for purple cells surrounded by a clear halo on a dark background. The halo is the capsule. You may need to decrease the amount of light in order to make the capsule easier to see.
B. Anthony’s stain method
- Place a single drop of crystal violet on a clean microscope slide, adjacent to the frosted edge.
- Using a flamed loop and sterile technique, add three loopful of test bacterium (any capsulated bacteria such as Klebsiella pneumoniae, Streptococcus pneumoniae) from broth culture. If you are adding bacteria from a culture plate make sure that there are no large clumps of the organism, but try to avoid spreading the drop.
- Place the end of another clean microscope slide at an angle to the end of the slide containing the organism. Spread out the drop out into a film. This is done by contacting the drop of crystal violet with the clean microscope slide and using the capillary action of the dye/ slide to spread the crystal violet across the smear.
- Allow the film to air dry (will take 5-7 minutes). DO NOT heat or blot dry! Heat will melt the capsule!
- Tilt the slide and rinse with 20% copper sulfate solution. DO NOT RINSE WITH WATER! Water will remove the capsule from the cell.
- Let the slide air dry for a few minutes. DO NOT blot the slide! Blotting will remove the bacteria from the slide and/or distort the capsule.
- Observe the slide under oil immersion.
Results: Look for purple cells surrounded by a clear or faint blue halo on transparent background. The halo is the capsule. You may need to decrease the amount of light in order to make the capsule easier to see.
Points to remember
- Clean your microscope with lens cleaner, removing all oil from lenses.
- Dispose of staining waste and slides in designated waste containers.
- Be cautious while handling the slide, since the organisms have not been killed.
References and further reading
- Microbugz . Capsule Stain. https://www.austincc.edu/microbugz/capsule_stain.php
- Color Atlas and Textbook of Diagnostic Microbiology, Koneman, 5th edition